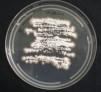

Dermatophytes are the main causative agent of all onychomycosis, but genus Microsporum is infrequent and the risk of acquiring the infection is often associated with exposure to risk factors.
ObjectivesTo describe clinical characteristics of onychomycosis due to Microsporum onychomycosis in an urban population.
MethodsThis was a retrospective analysis of the epidemiological and clinical features of 18 Microsporum onychomycosis cases of a total of 4220 of onychomycosis cases diagnosed between May 2008 and September 2011 at the tertiary referral center for mycology in Guatemala.
ResultsEighteen cases of Microsporum onychomycosis (M. canis, n=10; M. gypseum, n=7; M. nanum, n=1) were identified (prevalence=0.43%). Infection was limited to nails only and disease duration ranged from 1 month to 20 years (mean=6.55 years). The toenails were affected in all cases except for a single M. gypseum case of fingernail. The most common clinical presentation was distal lateral subungual onychomycosis (12/18) followed by total dystrophic onychomycosis (5/18), and superficial white onychomycosis (1/18). M. gypseum presented in 6 cases as distal lateral subungual onychomycosis and in 1 case like total dystrophic onychomycosis. Five cases (27.78%) were associated with hypertension, diabetes, and psoriasis. Treatment with terbinafine or itraconazole was effective. Two cases of M. canis distal lateral subungual onychomycosis responded to photodynamic therapy.
ConclusionThis is the largest reported series of Microsporum onychomycosis and demonstrates such a disease in an urban population. In 27.78% of the cases risk factors for infection were associated to comorbid states. We also report the first 2 cases of successfully treated M. canis onychomycosis with photodynamic therapy and a rare case of M. canis associated dermatophytoma.
Onychomycosis is the commonest nail disease worldwide accounting for 50% of all nail disorders in some studies.1,2 Although it is not a fatal infection it can be associated with discomfort and negative self-image3 and can predispose to soft tissue infection, particularly cellulitis.4 Toenails are predominantly affected and the major risk factor is occlusive footwear. Consequently, the prevalence of infection is often higher in urbanized populations. Fingernail infection, which is less common, is usually associated with occupational exposure to wet-work. Nail diseases such as psoriasis or damage to the nail plate also predispose to infection as do comorbidities, particularly diabetes mellitus, peripheral arterial disease, and HIV infection. Patients may have more than a single risk factor for infection. The incidence of onychomycosis is rising as a result of increasing exposure to risk factors and predisposing comorbid states.5,6
Onychomycosis is caused by dermatophytes, yeasts, and non-dermatophyte molds. Dermatophytes are the main causative agent in temperate climates and account for 90% of toenail infections and at least 50% of fingernail infections. Trichophyton rubrum is the commonest isolated dermatophyte and is responsible for the majority of cases of toenail infection, followed by T. mentagrophytes and Epidermophyton floccosum. Fingernail onychomycosis is more commonly associated with yeast infection, particularly Candida. Epidemiological studies from the Tropics and regions with high humidity sometimes report a higher prevalence of non-dermatophyte infection for both toenail and fingernail onychomycosis. T. tonsurans has occasionally been associated with onychomycosis but M. canis, M. gypseum and M. nanum are extremely rare etiological agents and the risk of acquiring Microsporum infection is often associated with a history of exposure and presence of risk factors.6,7
We have observed an increasing prevalence of onycomycosis in Guatemala. We presume this is due to urbanization which is associated with risk factors for onychomycosis. We have also noticed several cases of Microsporum onychomycosis in a relatively short period of time and the aim of this study was to define the disease characteristics of Microsporum nail infection within our cohort, its clinical course, and any risk factors for infection.
Materials and methodsThis is a retrospective study conducted at a tertiary referral center for mycology at the “Instituto de Dermatología y Cirugía de Piel Prof. Dr Fernando A. Cordero C.” in Guatemala City, Guatemala. Eighteen cases of mycologically proven onychomycosis were identified between May 2008 and September 2011. The diagnosis of onychomycosis was confirmed by direct microscopy using 10% potassium hydroxide and cultured using Sabouraud dextrose agar with chloramphenicol. Following mycological confirmation patients were treated with standard drug therapy regimens. Three-month courses of either daily oral terbinafine (250mg daily) or pulse itraconazole (200mg twice daily for one week every month) were most commonly used. Oral fluconazole was sometimes given at a weekly dosage of 300mg as it is a low cost and more affordable option for some patients. Two patients with M. canis distal lateral subungual onychomycosis (DLSO) aged 66 and 74 years were treated with photodynamic therapy (PDT) using 5-aminolevulinic acid (ALA) as PDT is not known to have any adverse systemic effects. Both patients received a maximum of four PDT sessions given at weekly intervals at a wavelength of 630nm at 57.6J/cm2 using a light-emitting diode (LED) PDT with red light. Clinical cure was verified by confirming mycological cure. Any atypical cases of onychomycosis were investigated for underlying HIV infection or other causes of immunosuppression, including long-term immunosuppressant drug therapy. A history of medical risk factors and occupational exposure was sought. Epidemiological and clinical data were collected for all cases of Microsporum onychomycosis. The study did not require an approval from the Ethics Committee.
ResultsA total of 4220 cases of mycologically proven onychomycosis were identified during a period of 41 months between May 2008 and September 2011. Eighteen of these cases were of the genus Microsporum, representing 0.43% of the total number of onychomycosis cases (18/4220). The majority of the rest of the cases were due to T. rubrum. Table 1 summarizes all characteristics of patients with Microsporum onychomycosis.
Characteristics of patients with Microsporum onychomycosis.
| Case | Sex | Age (years) | Clinical subtype | Disease duration (years) | Direct microscopy | Culture | HIV status | Comorbidities | Treatment | Response to treatment |
|---|---|---|---|---|---|---|---|---|---|---|
| 1 | F | 25 | DLSO | 1/4 | Hyphae | M. gypseum | Neg | No | Itraconazole | No follow-up |
| 2 | F | 48 | DLSO | 14 | Dermato-phytoma | M. canis | Neg | HT, DM | Flucoanzole, itraconazole | Cure |
| 3 | M | 42 | TDO | 1 | Hyphae | M. canis | Neg | No | Itraconazole | No follow-up |
| 4 | M | 49 | WSO | 10 | Hyphae | M. canis | Neg | No | Itraconazole | No follow-up |
| 5 | M | 74 | TDO | 4 | Negative | M. canis | Not tested | HT | Terbinafine | Cure |
| 6 | M | 24 | DLSO | 12 | Hyphae | M. gypseum | Not tested | No | Itraconazole | No follow-up |
| 7 | F | 74 | DLSO | 5 | Hyphae | M. canis | Neg | HT | PDT | Cure |
| 8 | F | 66 | DLSO | 1/2 | Hyphae | M. canis | Neg | HT | PDT | Cure |
| 9 | M | 32 | DLSO | 15 | Hyphae | M. gypseum | Neg | Psoriasis | Itraconazole | No follow-up |
| 10 | F | 8 | DLSO | 1/2 | Hyphae | M. canis | No tested | No | Terbinafine | Cure |
| 11 | M | 61 | DLSO | 1/12 | Spores | M. canis | No tested | No | Itraconazole | No follow-up |
| 12 | F | 52 | DLSO | 7 | Spores | M. canis | No tested | No | Fluconazole and timole | No follow-up |
| 13 | M | 29 | DLSO | 1/2 | Hyphae | M. gypseum | No tested | No | Terbinafine | Cure |
| 14 | F | 49 | TDO | 20 | Hyphae | M. canis | Not tested | No | Terbinafine | Cure |
| 15 | M | 18 | DLSO | 3 | Hyphae | M. gypseum | Not tested | No | Terbinafine | No follow-up |
| 16 | F | 61 | TDO | 10 | Hyphae | M. gypseum | No tested | No | Terbinafine | No follow-up |
| 17 | F | 38 | DLSO | 10 | Hyphae | M. gypseum | No tested | No | Terbinafine | No follow-up |
| 18 | F | 35 | TDO | 5 | Hyphae and Spores | M. nanum | No tested | No | Itraconazole | Cure |
DM, diabetes mellitus; DLSO, distal lateral subungual onychomycosis; F, female; HT, hypertension; M, male; Neg, negative; PDT, photodynamic therapy; TDO, total dystrophic onychomycosis; WSO, white subungueal onychomycosis.
All the Microsporum cases were positive on culture and 17 of 18 of them were also positive on direct microscopy. Interestingly, direct microscopy of a case subsequently confirmed on culture as M. canis demonstrated dermatophytoma. Ten of the 18 cases were due to M. canis (prevalence 0.24%), the other seven were due to M. gypseum (prevalence 0.17%), and the remaining case was due to M. nanum (0.024%) (Figs. 1 and 2).
There was no significant difference in gender distribution: eight males and 10 females were affected. M. canis affected both men (4/10) and women (6/10) as did M. gypseum (four males and three females affected) and M. nanum (one female affected). Seventeen cases were adult patients and one case was a boy patient. M. canis affected a group of people with an age range of 8–74 years (mean 52.3 years); M. gypseum, an age range of 18–61 years (mean 32.43 years), and M. nanum affected only one person. All patients had toenail onychomycosis except for one patient with M. gypseum onychomycosis affecting a single fingernail, who was a young man with a twelve-year history of nail infection but with no predisposing risk factors for onychomycosis (case 6 in Table 1). The most common clinical presentation was DLSO (12/18) followed by total dystrophic onychomycosis (TDO, 5/18) and superficial white onychomycosis (SWO, 1/18). M. gypseum presented mostly as DLSO (6/7) whereas M. canis had varied clinical presentations and M. nanum only presented as TDO (1/18) (Fig. 3).
The duration of Microsporum onychomycosis prior to presentation at our Institute varied widely, from one month to 20 years (mean 6.55 years). Only three patients sought medical care with disease duration of one year or less, one of them had M. gypseum onychomycosis. The others had suffered from onychomycosis for many years. None of the patients had tinea affecting other parts of their body such as tinea corporis or tinea capitis. Seven of the 18 patients were screened for HIV infection and were found to be negative. The 11 patients who were not tested for HIV did not display any signs of immunodeficiency. None of the patients had any other cause of immunodeficiency nor had they been on any immunosuppressant therapy. They did not have current or prior contact with domestic cats and dogs. Although in Guatemala households commonly keep animals close contact with animals is unusual and was not reported by any of our patients. Four patients suffered from hypertension, one of them also had diabetes mellitus. Our patients with hypertension had not been investigated for peripheral arterial disease, which is a significant risk factor for onychomycosis, although both conditions are known to be strongly associated. A single patient suffered from psoriasis, which affects both skin and nails.
Treatment responses were generally good, although we were not able to confirm mycological cure in some patients who failed to return for follow-up. Only a single patient in our cohort with a 14-year history of M. canis DLSO and an associated dermatophytoma was treated with oral fluconazole. She failed to respond after six months of weekly fluconazole therapy, but subsequently demonstrated both clinical and mycological cure following three months of pulse itraconazole therapy. Pulse itraconazole was given to seven other patients, including the three patients with M. gypseum, three further cases of M. canis, and one case of M. nanum. Two cases of M. canis and one case of M. gypseum treated with terbinafine demonstrated clinical and mycological cure as did the two cases of M. canis DLSO treated with a total of four sessions of PDT each.
DiscussionMicrosporum sp. as an infrequent agent of onychomycosis is. Our study of a Central American urban population demonstrated a prevalence of only 0.43% for M. canis, M. gypseum, and M. nanum nail infection. There are few recent comparative studies describing case series of Microsporum onychomycosis. An early study of onychomycosis from Mexico identified a prevalence of 3% of M. canis infection (of 733 onychomycosis cases).8 In Turkey, M. canis onychomycosis was identified in 8% of cases (6/73).9 Another study in 375 patents with onychomycosis in Taiwan seven cases of Microsporum onychomycosis were found (M. ferrugineum, n=5; M. nanum, n=2), representing 1.87% of the causative pathogens in that population. M. gypseum as a cause of any dermatophytosis is much less common than M. canis. Studies from Spain and Italy have found M. gypseum prevalence of 1.5–5.2% among all cases of dermatophytoses.10,11 However, a recent study of onychomycosis in rural farmers in Nigeria revealed a prevalence of 11.6% of M. gypseum DLSO (eight cases out of a total of 261 cases of onychomycosis) but no cases of M. canis infection.12 This high prevalence of M gypseum onychomycosis in this particular population is probably attributable to occupational exposure to soil as M. gypseum is a geophillic dermatophyte. Although these studies appear to demonstrate much higher prevalence for Microsporum onychomycosis, their sample sizes were smaller than ours.
The prevalence of onychomycosis varies throughout the world and risk factors for its development include the use of occlusive footwear in urban populations and high levels of environmental humidity. Our patient population fulfills both of these categories and consequently we see large numbers of patients with onychomycosis. In addition, significantly higher levels of onychomycosis have been reported in pediatric populations in both Guatemala as well as in neighboring Mexico compared with other more temperate regions of the world.13
The genus Microsporum is distributed worldwide and M. canis is the most common zoophillic species to affect humans, primarily causing tinea capitis in children. Domestic dogs and cats are usually the reservoir of infection and are often healthy carriers of Microsporum. In adults, unusual clinical presentations of M. canis infection have been described such as severe and inflammatory tinea barbae and very atypical tinea faciei,14 and M. canis infection in adults has often been associated with immnosuppressive states.15 Patients with M. canis onychomycosis may also report owning domestic cats or dogs and sometimes they have concomitant M. canis tinea corporis or tinea capitis which can occur from autoinoculation.16–19M. canis onychomycosis has also been reported in association with HIV infection15 and long-term immunosupressant drug therapy18M. gypseum is a soil saprophyte and the source of human infection has been traced to soil, dogs and cats.20 Other than occupational exposure as described in the report of high levels of infection among rural Nigerian farmers,12 the rising incidence of M. gypseum infections may be attributable to the domestication of dogs and cats, which causes soil contamination and increases the risk of infection to humans. It has also been suggested that M. gypseum may be undergoing phylogenetic evolution from a geophillic saprophyte to a human and animal parasite.21 The most frequent clinical presentation of M. gypseum infection is tinea corporis on exposed areas of the body followed by tinea capitis, which is sometimes associated with kerion formation.
The clinical subtypes of onychomycosis seen in our study correlate with previously reported studies of nail infection with Microsporum sp. with DLSO being the most common clinical presentation followed by TDO and SWO, and rarely PSO.17–19 All our cases of M. gypseum infection presented as DLSO. This is the main clinical subtype described in earlier studies22,23 although there is also a report of M. gypseum infection presenting as TDO24 and a further report of M. gypseum PSO in an immunocompetent host.25 Fingernail infection was uncommon in our cohort which included only a single case of fingernail M. gypseum DLSO in a young man without apparent risk factors. However, previous studies of M. gypseum onychomycosis report fingernails being affected in nearly all cases, and disease was usually reported in young women although no risk factors for infection were suggested.22
Reported cases of M. canis onychomycosis associated with immunosuppressive states have been of the common DLSO clinical presentation,18 although immunosuppression-associated onychomycosis usually presents with either PSO or WSO.5 Paradoxically, there are also reports of M. canis onychomycosis in immunocompetent individuals presenting as PSO,16,17 and herein we also report a case of M. canis WSO in an immunocompetent patient. These observations suggest that not only is Microsporum onychomycosis uncommon but that clinically it may be atypical.
Our study has thrown up further interesting observations. Firstly, direct microscopy demonstrated a dermtophytoma from a single patient whose culture subsequently confirmed to be M. canis. This is extremely unusual as M. canis producing dermatophytomas has not been previously reported. Furthermore, dermatophytomas are a poor prognostic sign and generally do not respond favorably to drug therapy as they consist of a densely packed clump of dermatophyte hyphae which are thick-walled and therefore resistant to drug penetration.26,27 Yet, our patient who had a 14-year history of onychomycosis and also suffered from diabetes mellitus and hypertension demonstrated both clinical and mycological cure after a standard three-month course of pulse itraconazole. She had previously failed to respond satisfactorily to a six-month course of fluconazole 300mg weekly but higher doses and a longer period of treatment with fluconazole is usually required to achieve cure.28 It is also possible that nail sampling for mycology from this patient physically removed the dermatophytoma which facilitated cure.
Our study also reports the first successfully treated cases of M. canis onychomycosis with PDT. In recent years the use of PDT has extended to the field of antimicrobial chemotherapy, in vitro studies having demonstrated PDT's antifungal effects.29 PDT is an attractive option as it is minimally invasive and only locally active and therefore does not cause systemic adverse effects or local tissue damage. Furthermore, unlike antimicrobial drugs there is no potential for the development of resistance. However, in an open trial of 30 patients with T. rubrum onychomycosis, three sessions of PDT given at two-week intervals produced only a 43.3% cure rate.30 In previous reports of T. rubrum onychomycosis being cured with PDT, a greater number of PDT sessions were given at shorter intervals.31,32 Our therapy regimen of four treatments given weekly may be the optimal treatment regimen for M. canis onychomycosis as it achieved clinical and mycological cure in both patients treated with this modality.
We report only one case of M. nanun onychomycosis. This dermatophyte is a rare cause of tinea in humans, but usually is present in pigs, its natural reservoir, and it has also been reported in cats, dogs and rabbits.33,34 Tinea corporis can be caused by M. nanun, but it is an exceptional cause of onychomycosis. We found a toenail onychomycosis in a 45-year-old woman with unknown source of infection and risk factors.35
We describe the largest case series of Microsporum onychomycosis to date. Although the prevalence of Microsporum onychomycosis in our study is not significantly higher than in other studies, these cases are notable for the absence of significant risk factors for Microsporum nail infection: only 55% (5/9) of our cases had concomitant diseases that could predispose to infection. Otherwise, other well-recognized risk factors associated with Microsporum onychomycosis such as underlying immunosuppressive states or contact with dogs and cats were not diagnosed or reported in any of our cases. This significant cluster of cases of these rare etiological agents of onychomycosis seen at our Institute may reflect an increasing incidence of Microsporum onychomycosis. The absence of any disease-associated risk factors in almost half of our cases suggests that Microsporum sp. may have greater affinity and pathogenicity for nail keratin than previously thought.
In only 18 cases of onychomycosis caused by Microsporum sp. it has been very difficult to point out special clinical characteristics.
Conflicts of interestThe authors declare no conflicts of interest.
The authors would like to thank Dary Gálvez, MD for the treatment of two of the patients with PDT and Mónica Hernández, MD for collecting all the data.
This study was realized in the “Unidad de Micología Médica” of the “Instituto de Dermatología y Cirugía de Piel Prof. Dr. Fernando A. Cordero C.” Guatemala City, Guatemala.